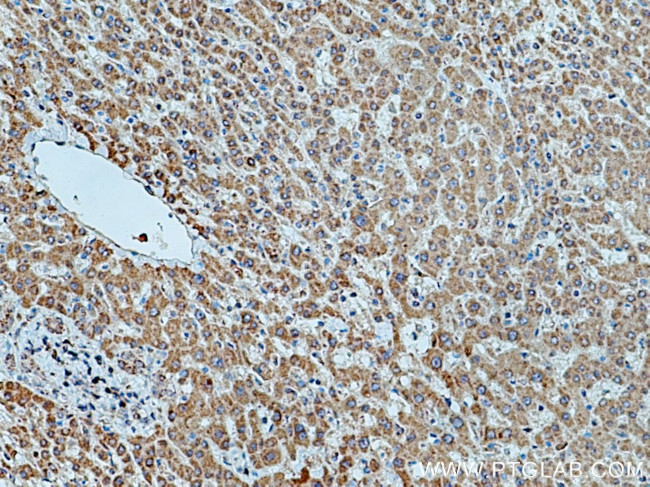
HMGCR Antibody in Immunohistochemistry (Paraffin) (IHC (P))

Search
Proteintech
HMGCR Polyclonal Antibody
{{$productOrderCtrl.translations['antibody.pdp.commerceCard.promotion.promotions']}}
{{$productOrderCtrl.translations['antibody.pdp.commerceCard.promotion.viewpromo']}}
{{$productOrderCtrl.translations['antibody.pdp.commerceCard.promotion.promocode']}}: {{promo.promoCode}} {{promo.promoTitle}} {{promo.promoDescription}}. {{$productOrderCtrl.translations['antibody.pdp.commerceCard.promotion.learnmore']}}
产品信息
13533-1-AP
种属反应
已发表种属
宿主/亚型
分类
类型
抗原
偶联物
形式
浓度
规格
纯化类型
保存液
内含物
保存条件
运输条件
产品详细信息
Immunogen sequence: TRGPVVRLP RACDSAEVKA WLETSEGFAV IKEAFDSTSR FARLQKLHTS IAGRNLYIRF QSRSGDAMGM NMISKGTEKA LSKLHEYFPE MQILAVSGNY CTDKKPAAIN WIEGRGKSVV CEAVIPAKVV REVLKTTTEA MIEVNINKNL VGSAMAGSIG GYNAHAANIV TAIYIACGQD AAQNVGSSNC ITLMEASGPT NEDLYISCTM PSIEIGTVGG GTNLLPQQAC LQMLGVQGAC KDNPGENARQ LARIVCGTVM AGELSLMAAL AAGHLVKSHM IHNRSKINLQ DLQGACTKKT A (588-888 aa encoded by BC033692)
靶标信息
3-Hydroxy-3-Methylglutaryl-CoA Reductase (HMGCR) is a key enzyme in the mevalonate pathway, which is critical for the biosynthesis of cholesterol and other isoprenoids. HMGCR catalyzes the conversion of HMG-CoA to mevalonate, a rate-limiting step in the production of cholesterol. Due to its central role in cholesterol synthesis, HMGCR is a primary target for statin drugs, which are used to lower cholesterol levels and reduce the risk of cardiovascular disease.
仅用于科研。不用于诊断过程。未经明确授权不得转售。
生物信息学
蛋白别名: 3-hydroxy-3-methylglutaryl CoA reductase (NADPH); 3-hydroxy-3-methylglutaryl coenzyme A reductase; 3-hydroxy-3-methylglutaryl-CoA reductase; 3-hydroxy-3-methylglutaryl-coenzyme A reductase; HMDH; HMG CoA reductase; HMG CoAR; HMG-CoA reductase; hydroxymethylglutaryl-CoA reductase; MGC103269; unnamed protein product
基因别名: 3H3M; HMG-CoAR; HMGCR; LDLCQ3; LGMDR28; MYPLG; Red
UniProt ID: (Human) P04035, (Mouse) Q01237, (Rat) P51639
Entrez Gene ID: (Human) 3156, (Mouse) 15357, (Rat) 25675